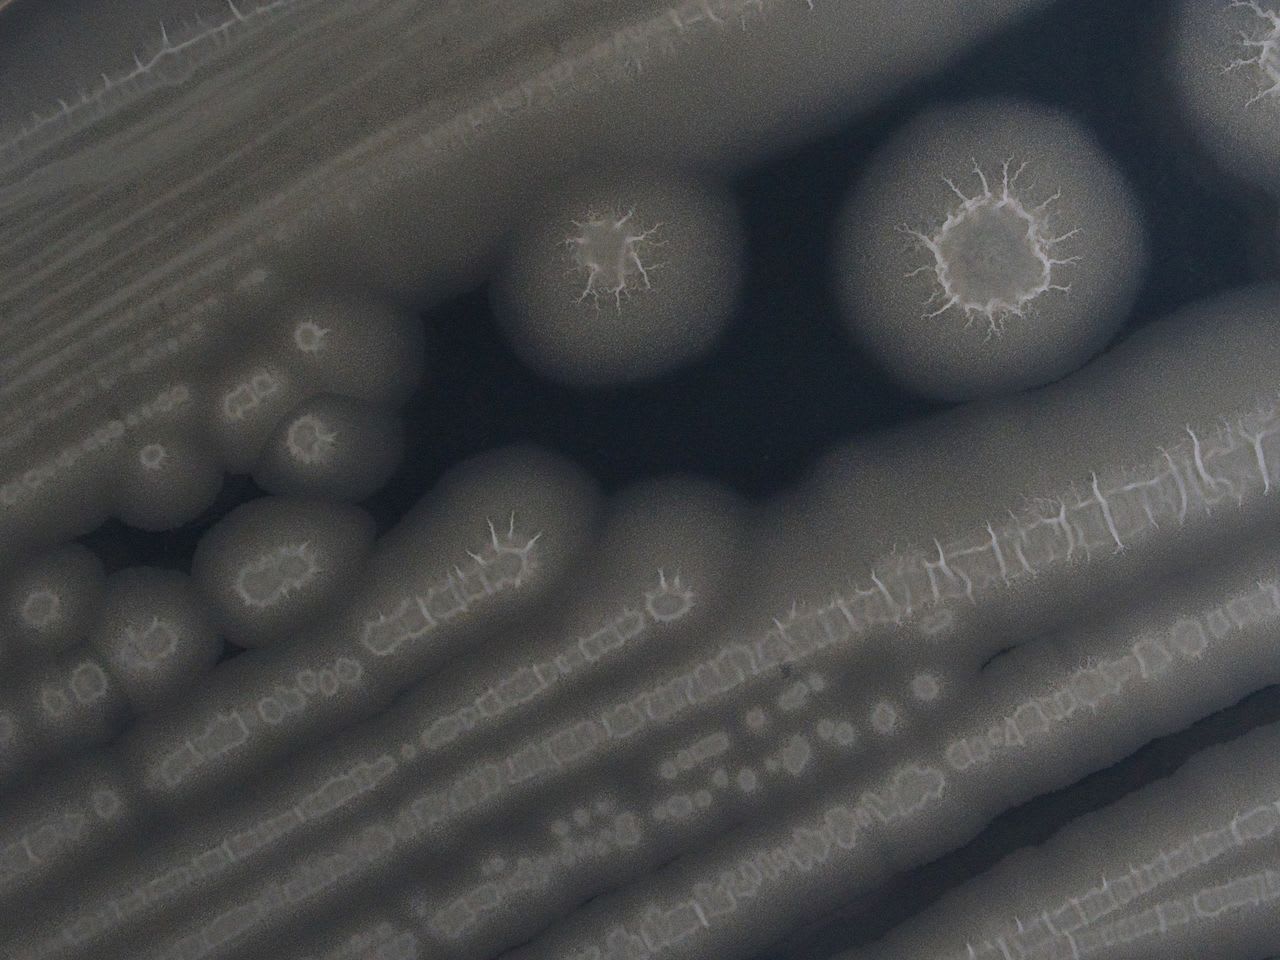

じつは、
多くの人が「あらゆる生物を吸っては、
吐いている」…
あまりに身近すぎる微生物は、
どこから来たのか。
例えば、
大阪で検証してわかった、
驚きの結果
私達の目には見えませんが、
空気中には多くの微生物が飛び交っています。
こうした空気中に存在する微生物
「大気微生物」は人類にとって
最も身近な微生物であり、
私達の健康にも少なからず影響を与えています。
さらに、
近年の研究では地球の気候、物質循環、
そして生命の誕生と進化にまで
大気微生物が貢献している
可能性が明らかになってきました。
そんな「見えざる小さな巨人」、
大気微生物とは一体どんな
生き物なのでしょうか?
その正体に迫ったブルーバックスの
『空飛ぶ微生物』から、
興味深いトピックの数々をご紹介していきましょう。
前回では、
大気中にいる微生物の存在を明らかにした、
伝説の飛行士リンドバーグと、
ある植物学者の逸話をご紹介しましたが、
今回は、そうした大気中にいる微生物が、
私たちにちっていかに身近な存在であるか、
ご説明しましょう。
こうした微生物が、
どこからやってくるのか、
著者が在住する大阪近傍での調査と、
その結果もご紹介します。
みんな、立派な人間ポンプ
21世紀になるまであまり注目
されてこなかった大気微生物ですが、
近年、空気中を漂う微生物が
実際に調べられるようになり、
事態が一転しました。
人は大量の微生物を肺で吸い込んで
吐く「人間ポンプ」だと判明したのです。
しかも、
人体に入り込む微生物の種類は
数百種以上に上ります。
そんなバカな、
微生物など吸っているものか!
と反論される方もいるかもしれません。
確かに、
無色透明の空気に微生物が
含まれているようにはみえません。
ところが、
微生物を育てる寒天培地を
空気にさらしておくと、
様々な微生物が生えてきて、
微生物の塊であるコロニーを形成します。
少なくともコロニーの数だけ、
生きている微生物が飛んでいるといえます。
コロニーを形成できる微生物は
全体のほんの一部であり、
生死を区別しないなら、
一般的なオフィスや学校の空気には
1ℓあたり約100以上の
微生物細胞が漂っています。
人の一呼吸の吸引量は平均0.5ℓなので、
一呼吸で肺に入る微生物は
少なくとも50個となります。
人の一日あたりの呼吸回数は
約2万5000回くらいであり、
一日あたり平均125万個もの
微生物を吸いこんでは、
吐いている計算になります
(少なく見積もって!)。
毎日、
肺の中では百万都市の
総人口が入れ替わる勢いで、
微生物細胞は呼気を通じて
人の体内を往来していることになります。
かつて金魚を飲み込んでは
再び口から出すという芸が
昭和の見世物小屋で流行り、
人間ポンプといわれていました。
100万以上の微生物を吸っては吐く人は、
立派な微生物の人間ポンプです。
風邪は、
偶然の繰り返しによる必然
鼻から吸引された微生物は、
皮膚や粘膜に接触し、
その多くは鼻毛や鼻の粘膜で
捉えられて鼻くそになります。
鼻毛は我々の体の防衛網(防衛毛?)といえます。
鼻くそができるということは、
埃とともに微生物を吸い込んでは吐いている
人間ポンプであるという証拠です。
そして、大きい鼻くそができるほど、
より多くの微生物の侵入を防いでいるといえます。
ただし、
一部の微生物は鼻の防衛網を突破し、
肺気道に入り込みます。気道に入り込んだ
微生物は、
ときとして肺の気管支で
アレルギーを引き起こし、
さらに肺胞にまで到達すると、
細胞成分を血流に混入させ
免疫不全を引き起こします。
もし感染症の原因菌であれば疾病に至ります。
1個体の微生物が感染症を引き起こす
可能性は偶然に近いのですが、
1日あたり125万個もの微生物を吸引していれば、
当たる確率も増します。
偶然の繰り返しによる必然です。
そのため、
人間ポンプである我々は、
だれしも風邪をひいた経験をもつのではないでしょうか。
人は、お互いに
微生物を交換しあっている
外から入り込む微生物に関心を抱きがちですが、
人の体自体も微生物を空気中に放散しています。
屋内の空気中を舞う微生物の約60%は、
在室の人に由来すると考えられています。
人は、皮膚や髪、呼吸器に生息する
微生物を大気中にまき散らして生活しており、
それが部屋の空気中を漂う微生物の源になるのです。
人は、独自の微生物を体にまとい、
皮膚の表面から数cm離れた空間まで、
特定の微生物群集(種組成)である
「微生物マトリクス」に覆われています。
実際に、
人体から空気中に放出される微生物の群集は、
個人ごとに種類や内訳が異なります。
人の皮膚や髪、呼吸器に生息する微生物群集が、
指紋のように個人個人で異なるため、
そこから漂う微生物群集も個人特有になるのです。
室内に複数人が滞在すると、
空気を通じて、
お互いの微生物マトリクスを
吸引しあっているといえます。
屋内空気の多くを占める浮遊粒子は、
衣服のほころびから生じる繊維片です。
床の埃も、大部分は衣服の繊維が起源です。
空気中を漂う繊維片には、
その衣服を着用していた人由来の微生物
(個人個人の微生物マトリクス)も付着しています。
年頃の娘さんがお父さんと洗濯物を
にしないでほしいと懇願する話を耳にしますが、
同じ屋内で生活していると、
既にお互いの衣服の繊維がふれあい、
微生物マトリクスまで交換しあっているのです。

土壌や海洋にはまったく
及ばないけれど、
もっとも身近な微生物
しかし、こんなに人に身近であり、
話題に事欠かない微生物であるにもかかわらず、
大気微生物について本格的に
研究が始まったのは21世紀に入ってからです。
それまで、
病原菌による空気感染について知見はあったものの、
通常の大気に浮遊する微生物については、
数も種もほとんど議論されませんでした。
これは、微生物を詳しく調べる技術が
不十分であったこともありますが、
そもそも大気中を浮遊する微生物が、
地球全体の微生物量に占める割合が極小だからです。
地球の全大気に浮遊する微生物量は、
おおむね10¹³細胞であるのに対し、
土壌と海洋に生息する微生物の総細胞数は
いずれも10²⁹細胞のオーダー
(土壌微生物:2.3×10²⁹細胞、
海洋微生物:1.9×10²⁹細胞)にものぼり、
大気の微生物総量は土壌や海洋と比べると
0.00000000000001%(10¹⁶個分の1)に過ぎません。
そのため、微生物が発見されてから200年間、
物量の多い土壌や海洋の微生物のみが注目され、
大気微生物の存在は無視されてきました。
ところが実際には、
人が日常的に触れて影響を受けるのは、
土壌や海洋の微生物よりも、
圧倒的に大気中の微生物です。
我々の呼気を通じて体内を通過する微生物量は、
繰り返しになりますが一日約125万個です。
漁業や農業に従事していなければ、
日常生活で海洋や土壌の
微生物を直接摂取するのはまれです。
我々は大気微生物に包まれて生活しているため、
大気微生物は当たり前の存在となり
見落とされてきたともいえます。
あなたが吸い込んでいる
大気微生物は、
どこからやってきた?
人は微生物を吸引するとき、
常に一定のペースで微生物を
吸い込んでいるわけではありません。
多い瞬間もあれば、
少ない瞬間もあります。
私たちの周辺を浮遊する微生物の密度は
1m³あたり100個から10万個くらいの
範囲で変動するからです。
空気循環で大気粒子の密度は刻一刻と変わり、
空気中の微生物の密度も
環境条件によって激変します。
人の生活圏では、
人の往来が多いと大気粒子が増え、
微生物も舞います。
前述したように、室内大気を浮遊する微生物は、
主に人から発生しますが、屋外では、
農耕地や下水処理場、非舗装の道路、
ガーデニング、
道の吹き溜まりなどが発生源になります。
道端に落ちている犬の糞や虫の死骸などからも
大気微生物が生じます。
自然環境の海や森、
砂漠は大気微生物の宝庫であり、
風だけでなく、
湿度や気温の変化によっても、
地表面や植物から微生物が大気中に
断続的に供給されています。
しかも、街に住んでいても海や森、
砂漠からの微生物にさらされています。
空気は数千kmも離れた長距離を移動し、
微生物を運んでくるからです。
では、今、
あなたがいる場所の大気微生物は
どこから来たのでしょうか?
ある地点に飛来した気塊(きかい。空気のかたまり)の
発生源を特定するには、
空気の流れをシミュレーションしてくれる
後方流跡線解析が秀逸です。
この解析はNOAA(アメリカ海洋大気庁)の
Webサイトで一般の方も利用でき、
解析結果の地図をみれば、
今、自分のいる場所の空気が
どこから来たかがわかります。
筆を取っている2025年3月25日現在、
筆者がいる近畿大学東大阪キャンパスの
上空2000mの空気がどこから来たのかを、
3日前からさかのぼってみましょう
(図「近畿大学を終点にした後方流跡線」)。
近畿大学を終点にした後方流跡線
後方流跡線の解析図では、
ゴビ砂漠から大阪まで空気の流れを示す線が
伸びているのがわかります。
3日前にゴビ砂漠を漂っていた空気が
大阪に移動してきたようです。
その証拠に、ゴビ砂漠で発生した砂塵も
空気と一緒に届き、
現在の大阪では黄砂が生じ、
空が黄色くよどんでいます。
あなたは、世界の微生物と、
大気でつながっている
我々の生活空間である屋内の体積を
すべて足し合わせても、
地球の全大気の0.0001%(100万分の1)にすぎません。
このわずかな生活空間で、
人は一日の半分は過ごしているのです。
屋内空間を漂う微生物は、
主に人が起源と述べましたが、
部屋に外気が入り込むと話が違ってきます。
屋内外を人が出入りすると、
屋外の空気の一部、つまり全大気の
99.9999%の空気が部屋に舞い込み、
屋内にいても、
街や遠く離れた自然界から
来訪した微生物にもさらされます。
驚きの生命体「大気微生物」の世界へようこそ!
人が吸いこむ微生物の数は、
なんと1日平均125万個。目には見えないが、
空気中には多くの微生物が飛び交っているのだ。
こうした大気中の微生物は、我々の健康のみならず、
気候、地球上の物質循環、
生命の起源と進化にも影響を与えている。
さらには宇宙に飛び出し、
新たな惑星の生命誕生のきっかけになる
可能性すらあるという。